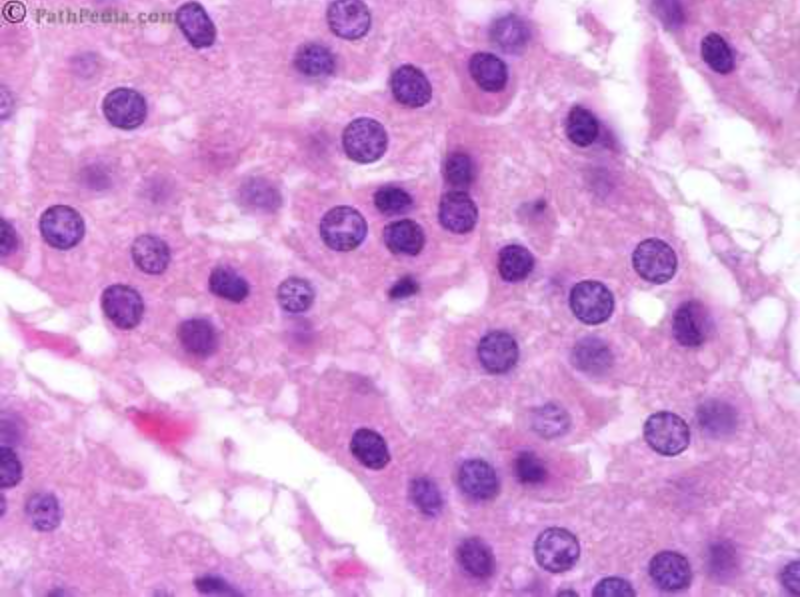

Identify the blood vessel:

•Both ducts and vessels are tubular structures; the difference is in the epithelial lining. The epithelial lining of a blood vessel is designed to allow diffusion of substances into and out of the vessels, so it is squamous epithelium: a thin, permeable layer (as a side note, the epithelial lining in a blood vessel is called “endothelium”). The epithelial lining of a duct is designed for secretion, so the cell has to be bigger to house the secretory machinery, so it is cuboidal or columnar epithelium.

Select the endocrine portion of this organ:


Select the exocrine portion of this organ:


Identify the lamina propria

Lamina propria is another name for the loose connective tissue that supports epithelium. It is NOT the same thing as the basement membrane, which is a specialized area of connective tissue between the epithelium and lamina propria.

Select the layers of the colonic mucosa:
Epithelium
Lamina propria
Muscularis mucosa
Submucosa
Muscularis propria
Serosa
Epithelium
Lamina propria
Muscularis mucosa
All segments of the GI tract are divided into four layers: the mucosa (epithelium, lamina propria, and muscular mucosae), the submucosa, the muscularis propria (inner circular muscle layer, intermuscular space, and outer longitudinal muscle layer), and the serosa. Mucosa is the innermost layer, which is structurally and functionally the most complex and important area. The mucosal surfaces of the body are the areas where important absorptive function occurs. The mucosa consists of three layers. The first layer facing the intestinal lumen is made up of epithelial cells, which is a single layer in the GI tract and is attached to a basement membrane overlying the second layer, the lamina propria, which consists of subepithelial connective tissue and lymph nodes, underneath which is the third and deepest layer called muscularis mucosae. This is a continuous sheet of smooth muscle cells that lies at the base of the lamina propria. The entire mucosa rests on the submucosa, beneath which is the muscularis propria. The outermost layer is named as the serosa or, if it lacks an outer layer of mesothelial cells, the adventitia. The submucosa consists of a variety of inflammatory cells, lymphatics, autonomic nerve fibers, and ganglion cells. This area is also a branching and distribution zone for arteries and small venous channels.
Identify the blood vessel

Adipocytes usually appear under the microscope as empty spaces because fat does not survive the usual slide preparation process. Notice the flattened cell nucleus adjacent to the open space. The blood vessel is sometimes an empty space surrounded by numerous flattened (squamous) nuclei, plus muscle and/or connective tissue depending on how large the vessel is.

Which cells normally line the body cavities?
Melanocytes
Squamous epithelium
Stratified columnar epithelium
Dense connective tissue
Nervous tissue
Squamous epithelium
What leads to the phenomenon shown in this photo?

Dysfunction of the tight junctions
Dysfunction of the gap junctions
Dysfunction of the hemidesmosomes
Dysfunction of the stratum basale
Dysfunction of the dense connective tissue
Dysfunction of the tight junctions
The tissue most likely to be found in this area is
Stratified squamous epithelium
Simple cuboidal epithelium
Loose connective tissue
Dense connective tissue
Adipose tissue
Dense connective tissue
What type of muscle cells are found in the GI tract?
Cardiac myocytes
Skeletal muscle
Smooth muscle
Stratified muscle
Cuboidal muscle
Smooth muscle
The steps involved in obtaining this image include
Formalin fixation
Freezing
Heating
Staining with hematoxylin
Staining with silver
Paraffin embedding
Sectioning into thin slices
Sectioning into cubes
Formalin fixation
Staining with hematoxylin
Paraffin embedding
Sectioning into thin slices
What are protective mechanisms for cells in the GI tract?
Epithelial tight junctions
Mucous production
Production of bicarbonate to neutralize acid
Stratified architecture
All of the above
Identify the cell nucleolus


Identify the extracellular matrix


The part of the digestive system that produces bile is the
Gallbladder
Pancreas
Liver
Small intestine
Appendix
Liver
Chronic physical or chemical irritation leads to what change in the cell?
Atrophy
Angiogenesis
Apoptosis
Metaplasia
Hyperplasia
Metaplasia
The heart on the right is normal. The heart on the left shows
Atrophy
Hypertrophy
Metaplasia
Desquamation
Apoptosis

Hypertrophy
Stem cells for the skin are located in what layer?
Stratum basale
Dermis
Stratum corneum
Lamina propria
Stratum langerhans
Stratum Basale
What type of gland is depicted here?

Lamellar
Exocrine
Endocrine
Dermal
Islet
Endocrine